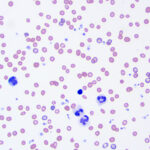

Peripheral blood and pyloric-duodenal mass aspirate from a cat
Case Information
A 15-year-old female spayed Domestic Shorthair cat was admitted as an emergency at the Cornell University Hospital for Animals for severe anemia. The cat had a one week history of hiding and hyporexia with one episode of vomition the day before presentation. On examination, the cat was stable but estimated to be 7% dehydrated. Point-of-care testing showed a severe anemia (packed cell volume, 9%) and hyperlactatemia 3.7 mmol/L (normal, <2 mmol/L). Blood was taken into EDTA- and non-anticoagulant tubes for a hemogram (see results below and Figures 1-2 for morphologic features of the blood cells) and small animal biochemical profile (see results below), respectively, before the cat was given a unit of packed red blood cells. Serum was separated from cells and the serum and EDTA-anticoagulated blood was stored refrigerated before submission to the clinical pathology laboratory the next morning.
The cat was transferred to the Small Animal Medicine Service the next day. A mass effect was palpated in the cranial abdomen. Abdominal ultrosonographic assessment revealed a mass at the pyloric-duodenal junction. A fine-need aspirate was taken of the intestinal mass under ultrasonographic guidance and submitted for cytologic assessment (Figures 3-5). View the images from blood and the intestinal mass and then answer the questions below.
- What red blood cell abnormalities are identified in the peripheral blood smear?
- What is the likely mechanism for the anemia in this cat?
- What is your cytologic diagnosis for the intestinal mass?
Answers on next page